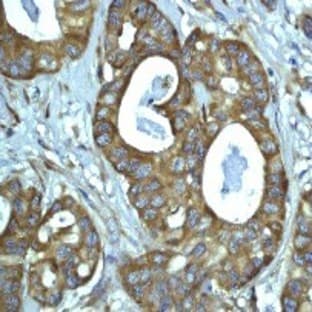
anti-BCL2 Binding Component 3 (BBC3) (C-Term) antibody

Supplier:
Antibodies-onlineCat no: ABIN258427
anti-BCL2 Binding Component 3 (BBC3) (C-Term) antibody
Prices direct from Antibodies-online
Quick response times
Exclusive Biosave savings/discounts
SPECIFICATIONS
Catalog Number
ABIN258427
Size
0.1 mL
Applications
FC, ICC, IHC, IHC-F, WB
Hosts
Rabbit
Reactivities
Hum
Clone
EP512Y
Antigen
PUMA
Gene Id
27113,170770,317673
Isotype
IgG
Clonality
Monoclonal
Entrez Gene Id
27113,170770,317673
More from Antibodies-online
Applications
DB, ELISA, IHC, WB
Hosts
Sheep
Applications
DB, ELISA, IHC, WB
Hosts
Sheep
Applications
ELISA, WB
Hosts
Goat
Applications
ELISA, WB
Hosts
Goat
Latest promotions
Spend less time on DNA cleanup so you can do more science. The MSB Spin PCRapace is the fastest way to purify your DNA from PCR, restriction digestion, and...
Use promo code EASY3 to receive 13% off and FREE shipping!Experience a new dimension of electronic pipetting with the NEW Easypet 3 pipette controller. The...
New brilliant antibodies, and new lower prices!For flow cytometry reagents in general, \"bright is better.\" The violet-excitable BD Horizon™ BV421 and...
As an incentive to qualify our BSA, we are offering a 20% discount when you purchase your first 100g, 500g or 1000g of any grade of Bovine Serum Albumin....
It is not every day that you are given something for nothing. We are giving away additional spectrophotometer software.Cecil Instruments have enhanced the...
Did your supplier increase the price of Fetal Bovine Serum? Did they substitute the US Origin with USDA? Well say no more! Innovative Research is still...
10% Discount on 2 Rabbit Polyclonal Antibody Service. With over 20 years experience, SDIX has developed into the premier US custom antibody producer,...
We're so sure that you'll prefer Cayman Assay kits over your present brand that we're willing to give you a free assay kit to prove it!
For the past decade scientists have extensively used ATS secondary toxin conjugates to make their own targeted toxins for in vitro use.The ability to combine...
Bulk Cytokines with Custom Vialing.20 - 50% off cytokines, growth factors, chemokines and more...For a limited time Cell Sciences is offering substantial...
Are you planning to have a customised antibody made for your research?Since 2000, Everest has been producing a catalog containing thousands of affinity...
Jenway’s 73 series spectrophotometer range provides four models with a narrow spectral bandwidth of 5nm and an absorbance range of –0.3 to 2.5A,...
Top suppliers

United States Biological
230753 products

Carl Zeiss Microscopy
27 products

Eppendorf
1 products

Promega Corporation
11 products

Panasonic Healthcare Company
5 products

Life Technologies
1 products

Nikon Instruments Europe
11 products

Olympus Europa Holding GmbH
3 products

Leica Microsystems, Inc.
10 products

GE Healthcare Life Sciences
2 products

Tecan Trading AG
19 products

Beckman Coulter, Inc.
1 products

AB SCIEX
3 products
BD (Becton, Dickinson and Company)
1 products

RANDOX TOXICOLOGY
5 products

Randox Food Diagnostics
6 products